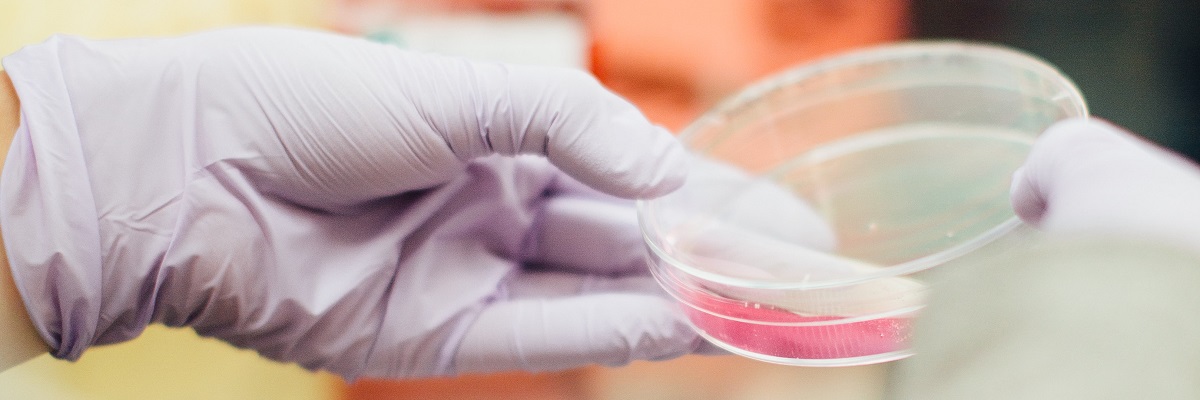
a person with gloves on holding a petri dish with chemical inside

|
||||||
|
||||||
|
||||||
|
||||||
The Five GCSE Pathway is a one-year course specifically designed for ambitious students who require a strong set of GCSE qualifications, including essential English and Maths, to progress onto a variety of science-based courses, including T Level Science or a range of A Levels.
If you are determined to pursue a career in science but need to secure your key grades first, this pathway provides the focused support, expert teaching, and dedicated structure you need to succeed.
Four GCSEs at grade 3 or above, including English Language, Mathematics and two Sciences.
To progress to Level 3 T Level Science or A Levels in science subjects you will need to meet the entry criteria below:
The programme is delivered across one academic year, with time allocated specifically to each of the five subjects. Learning is delivered through a combination of taught sessions and practical investigations.
The timetable is structured to ensure coverage of all five specifications while building study and revision skills.
Assessment for all five subjects is conducted via external examinations at the end of the academic year (May/June). You will sit examination papers for the five individual GCSE subjects.
The three separate sciences (Biology, Chemistry, Physics) are assessed entirely by written examination, but required practical activities are integrated throughout to ensure competency and preparedness for exam questions.
Succeeding in this course will allow you to progress onto a variety of courses, including T Levels or a range of A Levels. T Levels have UCAS tariff points and are fully supported by top universities. You could apply for degrees in Microbiology, Biomedical Science, Chemical Engineering, or Forensic Science. You could also use your T Level to fast-track into higher apprenticeships, earning a salary and a degree at the same time.